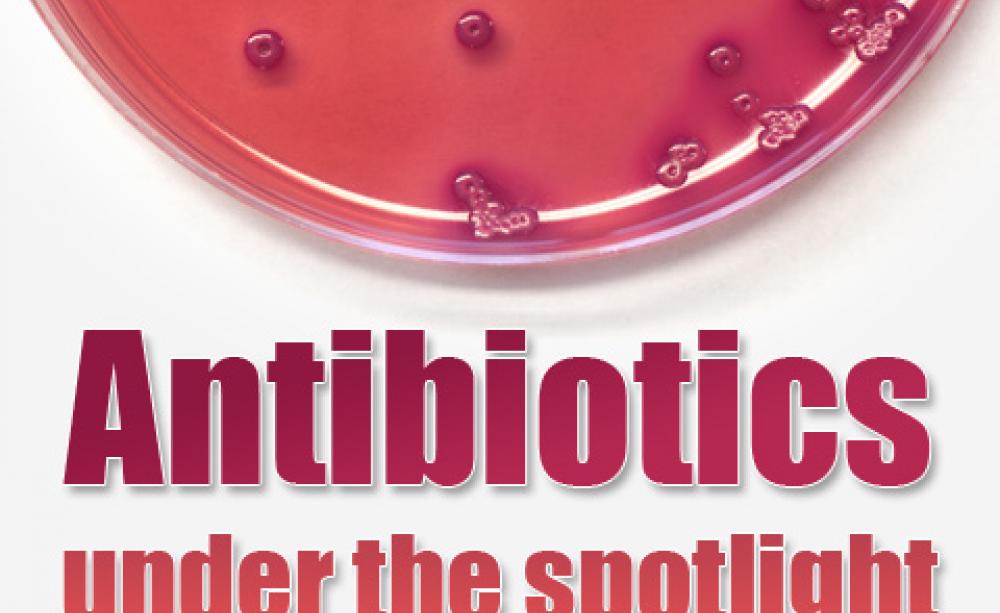
Antibiotics under the spotlight

The recent E.coli outbreak and the emergence of a new strain of MRSA in the UK dairy herd have put modern food supply and production chains in the spotlight like never before.
Scientists’ discovery earlier this month of the new - potentially deadly - MRSA bacteria in dairy cows (one almost identical to a strain recorded in human hospital patients) should be a particular cause for alarm.
Strains of MRSA, which causes infections in humans and is resistant to many existing antibiotics, have already been found in pigs, poultry and cattle in several other European countries, but this is the first hard evidence of MRSA being discovered in UK farm animals.
Claims that the disease’s emergence in the UK dairy herd could in fact be due to the now ‘routine’ antibiotic use in modern farming are even more worrying. As an Ecologist special report recently highlighted, there are increasing concerns about the spread of deadly antibiotic-resistant infections from animals to humans.
Health experts and campaigners say that the overuse of antibiotics in farming is contributing to the ever-increasing amount of antimicrobrial-resistance as bacteria evolve to withstand existing drugs.
This situation could have dire consequences for our current and future generation’s ability to treat disease and illness and urgently needs tackling: by farmers themselves, policy makers and governments, retailers, and by consumers - the power of economic pressure should not be understated.
Human medicine
Our focus on antibiotics also included an investigation into the sometimes terrifying - and sometimes deadly - adverse reactions linked to ciprofloxacin, a commonly prescribed fluoroquinolone class of antibiotic. Patients who say they were poisoned by the drug are demanding urgent action to prevent others suffering serious side effects; they want more research into adverse reactions, greater education of health professionals and clearer warnings for consumers.
Our investigation revealed that the antibiotic in question has been linked to more than forty deaths in the UK in recent years and been the subject of hundreds of suspected adverse reactions. Whilst this number is tiny compared to the huge numbers successfully treated - and lives saved - by the drug it makes the disturbing experiences of victims no easier to swallow and raises important questions about modern drug testing systems.
What’s interesting is that some people poisoned by ciprofloxacin say their symptoms flared up when eating certain foods, usually meat. It could be no coincidence then that fluoroquinolones are used to treat diseases in poultry, pig and cattle farming, and traces of the drugs have been detected in meat samples. Although experts say this is unlikely to represent a health risk, in light of what we’ve uncovered it should probably be of concern to us all.
| READ MORE... | |
 |
NEWS ANALYSIS 'Routine antibiotic use' linked to new MRSA strain found in UK dairy cows Fresh concerns over the spread of antibiotic-resistant infections from farm animals to humans have been raised after scientists find new strain of potentially deadly superbug in dairy cows |
 |
NEWS ANALYSIS News investigation Popular antibiotic ciprofloxacin linked to UK deaths Millions of us are successfully treated with ciprofloxacin and other fluoroquinolone antibiotics each year. But for some patients the drugs are linked to severe adverse reactions involving terrifying physical and mental health impacts. Andrew Wasley reports |
 |
NEWS ANALYSIS Adverse reactions lead US patients to ask 'just how safe are antibiotics?' A growing number of American patients say they've been poisoned by fluoroquinolone antibiotics. Not only has this ruined lives, they say, it's exposed the unhealthy relationship between some drug manufacturers and medical regulatory bodies. Carey Purcell reports |
 |
NEWS ANALYSIS Overuse of drugs in animal farming linked to growing antibiotic-resistance in humans Urgent calls from health experts to reduce antibiotic use on intensive farms are largely resisted by the agribusiness food lobby, who downplay its role in the spread of antibiotic resistance in humans. Tom Levitt reports |
 |
COMMENT The reason why this deadly E coli makes doctors shudder It is past time for health authorities to curb the antibiotic misuse that created the resistance of this aberrant E. coli strain |